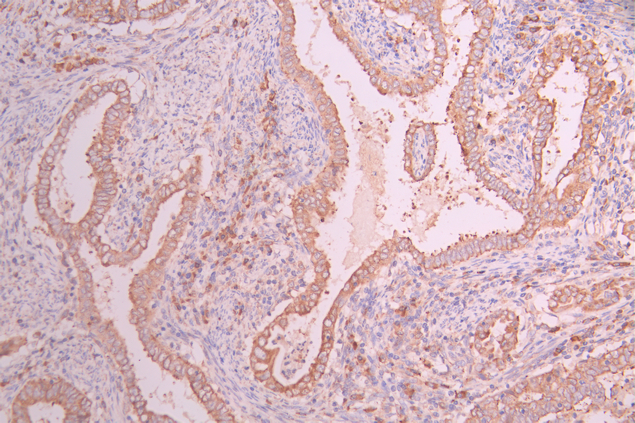

-
中文名稱:ALPL Recombinant Monoclonal Antibody
-
貨號:CSB-RA998339A0HU
-
規格:¥1320
-
圖片:
-
Western Blot
Positive WB detected in: LO2 whole cell lysate(30μg), HEK293 whole cell lysate(30μg), Hela whole cell lysate(30μg), HepG2 whole cell lysate(30μg), Mouse kidney tissue lysate(20μg), Rat kidney tissue lysate(20μg), Mouse liver tissue lysate(20μg)
All lanes: ALPL antibody at 1:1000
Secondary
Goat polyclonal to rabbit IgG at 1/40000 dilution
Predicted band size: 57 kDa
Observed band size: 75 kDa
Exposure time:2min -
IHC image of CSB-RA998339A0HU diluted at 1:100 and staining in paraffin-embedded human endometrial cancer/endometrial carcinoma performed on a Leica BondTM system. After dewaxing and hydration, antigen retrieval was mediated by high pressure in a citrate buffer (pH 6.0). Section was blocked with 10% normal goat serum 30min at RT. Then primary antibody (1% BSA) was incubated at 4°C overnight. The primary is detected by a Goat anti-rabbit polymer IgG labeled by HRP and visualized using 0.05% DAB.
-
IHC image of CSB-RA998339A0HU diluted at 1:100 and staining in paraffin-embedded human adrenal gland tissue performed on a Leica BondTM system. After dewaxing and hydration, antigen retrieval was mediated by high pressure in a citrate buffer (pH 6.0). Section was blocked with 10% normal goat serum 30min at RT. Then primary antibody (1% BSA) was incubated at 4°C overnight. The primary is detected by a Goat anti-rabbit polymer IgG labeled by HRP and visualized using 0.05% DAB.
-
Immunofluorescence staining of HepG2 cell with CSB-RA998339A0HU at 1:50, counter-stained with DAPI. The cells were fixed in 4% formaldehyde and blocked in 10% normal Goat Serum. The cells were then incubated with the antibody overnight at 4°C. The secondary antibody was Alexa Fluor 488-congugated AffiniPure Goat Anti-Rabbit IgG(H+L).
-
Overlay Peak curve showing Hela cells stained with CSB-RA998339A0HU (red line) at 1:100. The cells were fixed in 4% formaldehyde and permeated by 0.2% TritonX-100 for 10min. Then 10% normal goat serum to block non-specific protein-protein interactions followed by the antibody (1ug/1*106cells) for 45min at 4℃. The secondary antibody used was FITC-conjugated goat anti-rabbit IgG (H+L) at 1/200 dilution for 35min at 4℃.Control antibody (green line) was Rabbit IgG (1ug/1*106cells) used under the same conditions. Acquisition of >10,000 events was performed.
-
-
其他:
產品詳情
-
Uniprot No.:
-
基因名:
-
別名:AKP2 antibody; Alkaline phosphatase liver/bone/kidney antibody; Alkaline phosphatase liver/bone/kidney isozyme antibody; Alkaline phosphatase tissue nonspecific isozyme antibody; Alkaline phosphatase, tissue-nonspecific isozyme antibody; Alkaline phosphomonoesterase antibody; Alpl antibody; AP TNAP antibody; AP-TNAP antibody; APTNAP antibody; BAP antibody; FLJ40094 antibody; FLJ93059 antibody; Glycerophosphatase antibody; HOPS antibody; Liver/bone/kidney type alkaline phosphatase antibody; MGC161443 antibody; MGC167935 antibody; PHOA antibody; PPBT_HUMAN antibody; Tissue non specific alkaline phosphatase antibody; Tissue nonspecific ALP antibody; TNAP antibody; TNSALP antibody
-
反應種屬:Human, Mouse, Rat
-
免疫原:A synthesized peptide derived from human ALPL
-
免疫原種屬:Homo sapiens (Human)
-
標記方式:Non-conjugated
-
克隆類型:Monoclonal
-
抗體亞型:Rabbit IgG
-
純化方式:Affinity-chromatography
-
克隆號:16F4
-
濃度:It differs from different batches. Please contact us to confirm it.
-
保存緩沖液:Rabbit IgG in 10mM phosphate buffered saline , pH 7.4, 150mM sodium chloride, 0.05% BSA, 0.02% sodium azide and 50% glycerol.
-
產品提供形式:Liquid
-
應用范圍:ELISA, WB, IHC, IF, FC
-
推薦稀釋比:
Application Recommended Dilution WB 1:500-1:2000 IHC 1:50-1:200 IF 1:50-1:200 FC 1:50-1:200 -
Protocols:
-
儲存條件:Upon receipt, store at -20°C or -80°C. Avoid repeated freeze.
-
貨期:Basically, we can dispatch the products out in 1-3 working days after receiving your orders. Delivery time maybe differs from different purchasing way or location, please kindly consult your local distributors for specific delivery time.
-
用途:For Research Use Only. Not for use in diagnostic or therapeutic procedures.
相關產品
靶點詳情
-
功能:Alkaline phosphatase that metabolizes various phosphate compounds and plays a key role in skeletal mineralization and adaptive thermogenesis. Has broad substrate specificity and can hydrolyze a considerable variety of compounds: however, only a few substrates, such as diphosphate (inorganic pyrophosphate; PPi), pyridoxal 5'-phosphate (PLP) and N-phosphocreatine are natural substrates. Plays an essential role in skeletal and dental mineralization via its ability to hydrolyze extracellular diphosphate, a potent mineralization inhibitor, to phosphate: it thereby promotes hydroxyapatite crystal formation and increases inorganic phosphate concentration. Acts in a non-redundant manner with PHOSPHO1 in skeletal mineralization: while PHOSPHO1 mediates the initiation of hydroxyapatite crystallization in the matrix vesicles (MVs), ALPL/TNAP catalyzes the spread of hydroxyapatite crystallization in the extracellular matrix. Also promotes dephosphorylation of osteopontin (SSP1), an inhibitor of hydroxyapatite crystallization in its phosphorylated state; it is however unclear whether ALPL/TNAP mediates SSP1 dephosphorylation via a direct or indirect manner. Catalyzes dephosphorylation of PLP to pyridoxal (PL), the transportable form of vitamin B6, in order to provide a sufficient amount of PLP in the brain, an essential cofactor for enzymes catalyzing the synthesis of diverse neurotransmitters. Additionally, also able to mediate ATP degradation in a stepwise manner to adenosine, thereby regulating the availability of ligands for purinergic receptors. Also capable of dephosphorylating microbial products, such as lipopolysaccharides (LPS) as well as other phosphorylated small-molecules, such as poly-inosine:cytosine (poly I:C). Acts as a key regulator of adaptive thermogenesis as part of the futile creatine cycle: localizes to the mitochondria of thermogenic fat cells and acts by mediating hydrolysis of N-phosphocreatine to initiate a futile cycle of creatine dephosphorylation and phosphorylation. During the futile creatine cycle, creatine and N-phosphocreatine are in a futile cycle, which dissipates the high energy charge of N-phosphocreatine as heat without performing any mechanical or chemical work.
-
基因功能參考文獻:
- a significant proportion of adult heterozygotes for ALPL mutations may have unspecific symptoms not attributable to their heterozygosity. PMID: 29236161
- The ALPL SNP, rs1256328, was identified as being significantly associated with kidney stone disease status in a large Chinese Han cohort PMID: 29489416
- The expression of ALP mRNA and ALP activity in bone tissue were much higher in osteoporosis patients with fracture than those without fracture. PMID: 29786747
- genu varum is associated with the alkaline phosphatase level regardless of the presence of radiographic abnormalities in the growth plate in children. PMID: 28664247
- Adults with persistent hypophosphatasemia frequently harbor alkaline phosphatase mutations and have elevated ALP substrates. PMID: 28401263
- Mutations in ALPL which reduce alkaline phosphatase activity are responsible for Hypophosphatasia , a rare disorder characterized by defective bone and teeth mineralization and early tooth loss. PMID: 28570402
- These results show that an increase of TNAP activity in ACDC (arterial calcification due to deficiency of CD73) contributes to ectopic calcification by disrupting the extracellular balance of PPi and Pi and identify potential therapeutic targets for ACDC. PMID: 27965423
- the identification of 11 novel ALPL mutations in the five different HPP forms and the observation of a recurrent mutation, p. (Thr166Ile) in the Spanish population expand our knowledge of pathogenic ALPL mutations. PMID: 28127875
- Preoperative calcitonin levels were correlated with the presence of tumor, whereas alkaline phosphatase (ALP) levels were not. There were no significant associations between tumor volume and ALP or calcitonin levels in the preoperative or postoperative periods. During long-term follow-up, serum ALP was significantly associated with tumor recurrence, but serum calcitonin was not. PMID: 27922893
- His ALPL gene mutation came from c.228delG mutation in his mother and c.407G>A compound heterozygous mutation in his father PMID: 28506345
- Both PPARgamma gene expression and TNALP activity increased during intracellular lipid accumulation in HepG2 and 3T3-L1 cells. Inhibition of TNALP blocked intracellular lipid accumulation but did not alter expression of the PPARgamma gene. PMID: 28209522
- ALPL is a major contributor to the pathogenesis of Prostate cancer progression. PMID: 28006818
- This result indicated that the 1559delT mutant was not retained on the plasma membrane owing to a lack of the Glycosylphosphatidylinositol anchor. PMID: 27680481
- ALPL expression is significantly upregulated in human masticatory mucosa during wound healing PMID: 28005267
- serum ALP levels were not associated with increased death risk in prevalent HD patients over a 5-year interval. PMID: 27467278
- In conclusion, serum levels of BSP, ALP, ICTP, and PSA increased in patients with bone metastases, and combined detection of all markers could improve the positive-predictive value. PMID: 27323113
- results reveal that the amino acid substitutions at position 426 of TNSALP differentially affect the structure and function of TNSALP, leading to understanding of the molecular and cellular basis of hypophosphatasia. PMID: 28000043
- One-half of adult individuals with unexplained low serum ALP carried an ALPL mutation. The presence of a mutated allele was associated with tooth loss, slightly lower levels of serum ALP, higher levels of pyridoxal phosphate and phosphoethanolamine, as well as mildly increased serum phosphate. PMID: 26783040
- Dynamic changes of ALP, LDH and PSA during Abiraterone-therapy are associated with best clinical benefit and OS in bone metastatic castration resistant prostate cancer PMID: 26975660
- glycosylation differences in human bone alkaline phosphatases are of crucial importance for protein-protein interactions with collagen type I PMID: 26645431
- Analysis of a series of multiple N-glycan depletion mutants in TNSALP revealed that three N-glycans on N230, N271 and N303 were the minimal requirement for the structure and function of TNSALP and a prerequisite for its stable expression in a cell. PMID: 26797772
- The presence of TNAP increased the dynamics and decreased the ordering of model membranes. PMID: 26389140
- These data confirm that TNAP is co-expressed by dental pulp stromal cells together with other bone marrow stromal cells markers and show that cell density affects TNAP expression levels. PMID: 25636587
- ALP quartiles were significantly associated with albuminuria in participants with estimated glomerular filtration rate>120 90-119, 60-89 and <60 mL/min/1.73 Higher ALP levels are significantly associated with renal hyperfiltration PMID: 25853240
- during skeletal mineralization, the building Ca2+ gradient first activates TNAP, but gradually inactivates it at high Ca2+ concentrations, toward completion of mineralization. PMID: 25775211
- these data demonstrate that TNAP activity is significantly increased in the brain in both the sporadic and familial forms of Alzheimer's Disease (AD) and that TNAP activity is significantly increased in the plasma in AD patients PMID: 26219720
- A non-linear relationship exists between serum levels of ALP and phosphate and risk of total mortality from cardiovascular diseases. PMID: 25033287
- Higher alkaline phosphatase was associated with the short-term adverse outcomes of peritoneal dialysis-related peritonitis PMID: 25246707
- ALP mRNA binds to and is stabilized by vimentin. PMID: 25536665
- Elevated AP was associated with the presence of COPD and respiratory symptoms (cough, wheezing). PMID: 25336462
- Two-month alkaline phosphatase of <100 U/L had a negative predictive value of 97% for development of ischemic cholangiopathy after liver transplantation. PMID: 25769592
- A novel role of alkaline phosphatase in the ERK1 and ERK2 dephosphorylation in renal cell carcinoma cell lines PMID: 25241253
- In inflammatory cholestatic conditions, loss of activity of liver AP might promote hyper-adenosine triphosphate-bilia, lipopolysaccharide overload, and subsequent exacerbation and perpetuation of inflammation. [review] PMID: 25603770
- patterns were confirmed in human teeth, including widespread TNAP, and NPP1 restricted to cementoblasts lining acellular cementum PMID: 25504209
- High levels of alkaline phosphatase (a biochemical markers of osteosynthesis) is associated with poor prognosis in metastatic bone cancer from disseminated breast cancer. PMID: 25342482
- Polymorphisms in ALP, ENPP1 and ANKH are important genetic risk factors contributing to Pseudoxanthoma elasticum PMID: 25025693
- REVIEW: role of bone-type tissue-nonspecific alkaline phosphatase and PHOSPO1 in vascular calcification PMID: 24533943
- This family report indicates that mapping ALPL mutations within the gene does not necessarily help to predict the clinical severity of the hypophosphatasia phenotype. PMID: 24569605
- Data indicate that alkaline phosphatase (AP) velocity kinetics (APV)is an independent predictor of overall survival (OS) and bone metastasis-free survival (BMFS) in patients with -resistant prostate cancer (CRPC). PMID: 24929891
- the new role of ALP in cell viability and apoptosis and involvement in renal cell carcinoma tumorigenesis PMID: 24909115
- Effect of cyclic mechanical stimulation on the expression of osteogenesis genes in human intraoral mesenchymal stromal and progenitor cells. PMID: 24804200
- DNMT inhibitors facilitate the Pi-induced development of vascular calcification via the upregulation of the ALP expression along with a reduction in the DNA methylation level of the ALP promoter region. PMID: 24441913
- ABO locus is a major determinant for serum ALP levels in Chinese Han population. PMID: 24094242
- The CPT score,alkaline phosphatase > 1.5 ULN, and the CS nonresponse had an independent impact on the 90-day survival in alcoholic hepatitis. PMID: 24151614
- characterization of a novel genetic alteration (c.1318_1320delAAC, p.N440del) in the ALPL gene resulting in odonto-hypophosphatasia(HPP) in monozygotic twins; results assist in defining genotype-phenotype associations for odonto-HPP and identify the collagen-binding site as a region of potential structural importance for TNAP function in the biomineralization PMID: 23791648
- Serum ALP is adversely associated with measures of arterial structure and function in hypertensive African men. PMID: 22656046
- The Y28D, A111T and T389N mutants displayed only negligible ALP activity in vitro compared to the wild-type (WT) tissue-nonspecific alkaline phosphatase. PMID: 24022022
- The most frequent clinical type was the PLH type with prognosis related to respiratory failure, biochemical/radiological changes and ALPL mutations. PMID: 24276437
- The aim of this study was to investigate two mineralization-related genes TNAP and ANKH polymorphisms associated with ankylosing spondylitis (AS) in the North Chinese Han population. PMID: 23612078
- data suggest that the promineralization role of TNAP may be related not only to its accepted pyrophosphatase activity but also to its ability to modify the phosphorylation status of OPN. PMID: 23427088
顯示更多
收起更多
-
相關疾病:Hypophosphatasia (HOPS); Hypophosphatasia childhood type (HOPSC); Hypophosphatasia infantile type (HOPSI)
-
亞細胞定位:Cell membrane; Lipid-anchor, GPI-anchor. Extracellular vesicle membrane; Lipid-anchor, GPI-anchor. Mitochondrion membrane; Lipid-anchor, GPI-anchor. Mitochondrion intermembrane space.
-
蛋白家族:Alkaline phosphatase family
-
數據庫鏈接:
Most popular with customers
-
-
YWHAB Recombinant Monoclonal Antibody
Applications: ELISA, WB, IHC, IF, FC
Species Reactivity: Human, Mouse, Rat
-
-
-
-
-
-